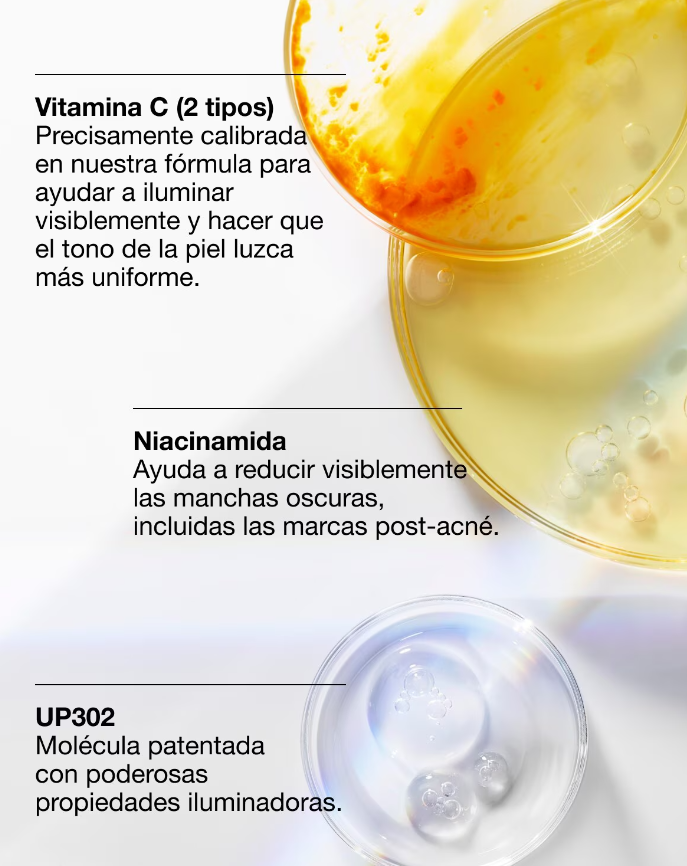

Autentika
Sérum Facial Unificador Even Better Dark Spot De Clinique Para Todo Tipo De Piel
Sérum Facial Unificador Even Better Dark Spot De Clinique Para Todo Tipo De Piel
No se pudo cargar la disponibilidad de retiro
Share
Reduce visiblemente las manchas oscuras, incluidas las manchas solares, manchas de la edad y marcas posteriores a los brotes.
El suero iluminador más avanzado de Clinique, diseñado para tratar la hiperpigmentación. Su fórmula avanzada, que incluye niacinamida y vitamina C, ofrece evidentes resultados de iluminación reduciendo visiblemente las manchas oscuras y marcas posteriores a los brotes.
Reduce visiblemente las manchas oscuras, incluidas las manchas solares, manchas de la edad y marcas posteriores a los brotes. Esta fórmula mejorada proporciona una exfoliación a nivel superficial y rompe el aspecto de la hiperpigmentación, como las manchas oscuras y el tono desigual. La piel se ve más luminosa y uniforme. Los ingredientes calmantes ayudan a calmar la piel, al reducir visiblemente la irritación que podría provocar futuras manchas oscuras.
Libre de:
-
Sometido a pruebas de alergias.
-
100% libre de fragancia.
-
Desarrollado por dermatólogos.
-
Probado por dermatólogos.
-
Probado por oftalmólogos.
-
Libre de aceite.
-
Libre de alcohol secante.
-
Libre de colorantes sintéticos
Tipo de piel:
-
Todo tipo de piel
-
Reduce visiblemente las manchas oscuras, incluidas las manchas solares, manchas de la edad y marcas posteriores a los brotes.